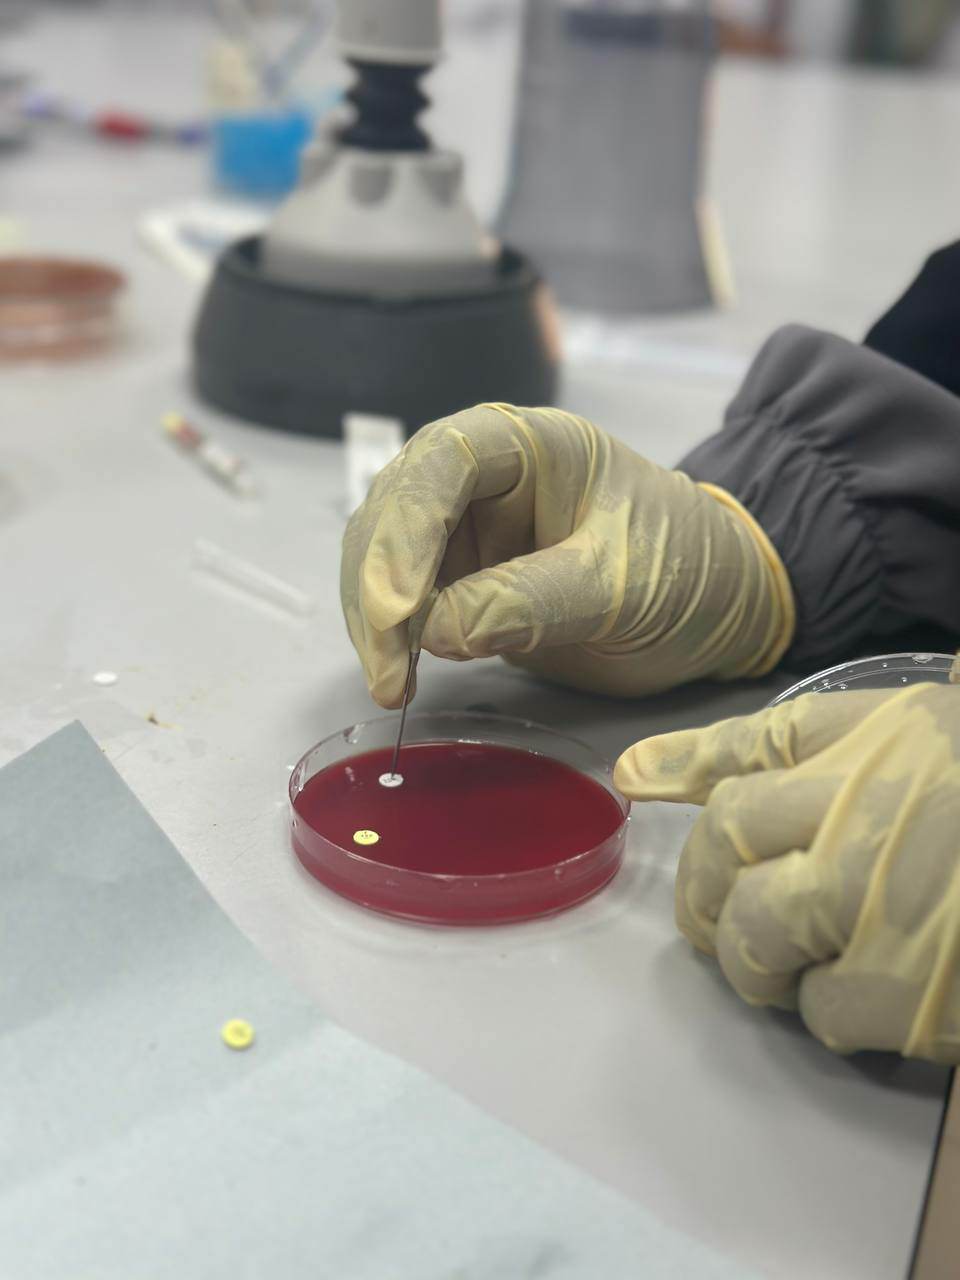

زيارة علمية بحثية لطلاب قسم العلوم الصيدلانية والمختبرات الطبية للمركز الليبي للبحوث الطبية
2023-10-16 |
بتنظيم وإشراف مركز البحث العلمي والتعاون الدولي, وبناء علي اتفاقية التعاون المشترك بين الجامعة ومركز البحوث الطبية بمدينة الزاوية
نفذ قسمي العلوم الصيدلانية والمختبرات الطبية اليوم الاتنين الموافق 16-10-2023 م زيارة علمية لمختبرات المركز ضمن التدريب العملي لمقررات علم الادوية والاحياء الدقيقة
حيث قام الطلاب بإجراء سلسلة من التجارب العملية ضمن مقررات المواد المذكورة اعلاه بإشراف باحثين من المركز بالتعاون مع اساتذة المقررات من ضمنها التجارب التالية:
- الطرق السليمة لمسك فئران التجارب
- سحب الدم من الفئران
- الطرق المتعددة لحقن الفئران
- تجربة اعطاء الدواء حسب الوزن
- استخدام دواء مخدر وحسب موعد احداث التخدير
- تشريح الفئران وسحب الدم من الشريان الاورطي
- تشريح اعضاء الجسم المختلفة
- زرع اطباف بكتيريا متعددة
الشكر موصول لادارتي الجامعة ومركز البحوث
جميع الحقوق محفوظة © جامعة طرابلس الأهلية 2023
برمجة وتصميم شركة طوارئ الحلول